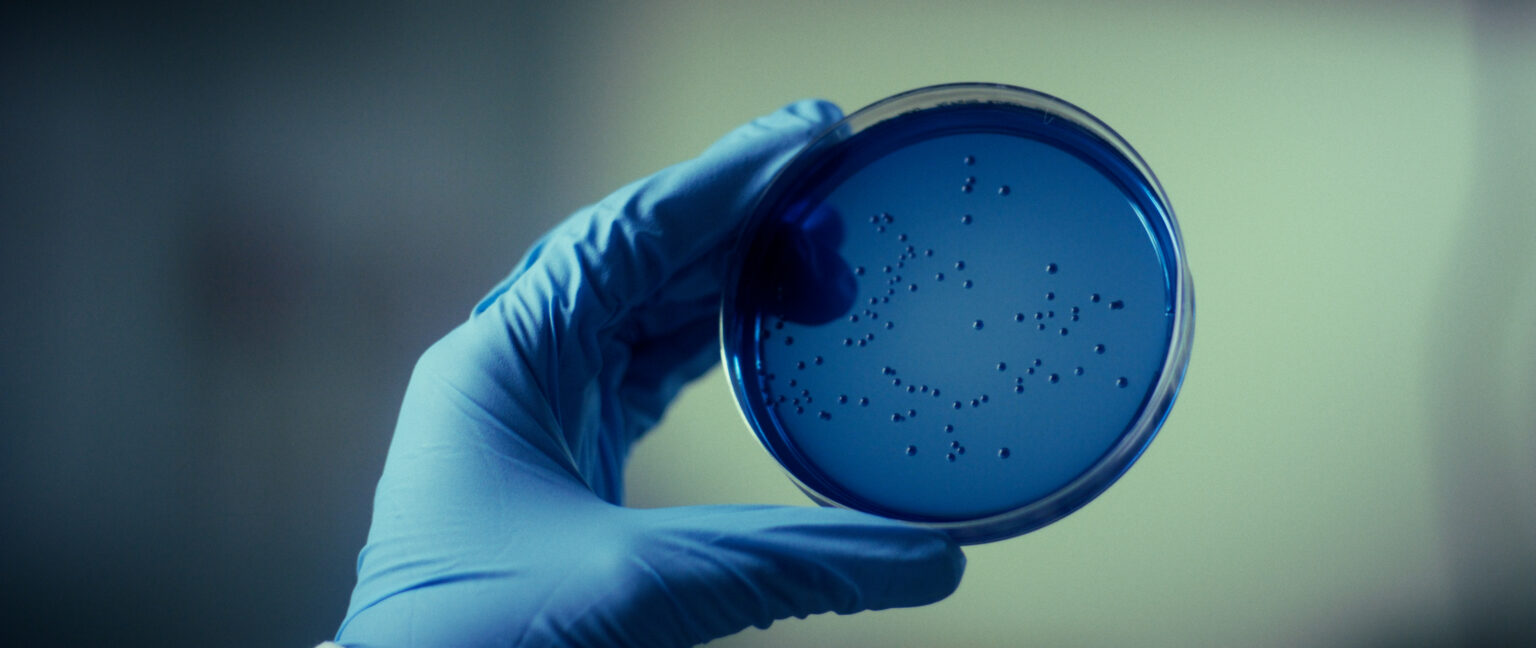

THIS WEBSITE IS FOR BUSINESS & INDUSTRY PARTNERS. FOR CONSUMER PRODUCTS VISIT : BLIS Probiotics >
THIS WEBSITE IS FOR BUSINESS & INDUSTRY PARTNERS. FOR CONSUMER PRODUCTS VISIT : BLIS Probiotics >
BLIS Q24™ (Micrococcus luteus Q24) is a patented and beneficial strain of bacteria naturally found in the skin. An innovative approach to managing skin concerns, BLIS Q24™ balances the skin microbiome, restoring the skin’s natural health, clarity and radiance.

Healthy, glowing skin starts with a strong, balanced skin microbiome.
The billions of microorganisms that make up the skin microbiome directly influence the moisture barrier. When the balance of bad bacteria overtakes the good, the skin barrier is compromised, causing dry, dull, sensitive and irritated skin.
Studies have found links between certain pathogenic bacteria in the skin and the prevalence of acne, skin aging and rosacea.*
After years of research and clinical trials, we have developed a solution based on microbiome science that utilises the power of live skin-specific probiotics to balance and restores the skin microbiome.

Chief Revenue Officer ENQUIRE NOW


Natural and gentle solution for skin concerns.

Produces broad-acting antimicrobial activity to inhibit pathogenic skin bacteria.

Crowds out pathogenic bacteria to balance the skin microbiome and restore the skin barrier.

Efficacious results in increasing hydration and reducing pore size, redness and impurities.

Microbiome analysis of skin swap samples showed the colonisation and crowding out power of BLIS Q24™. Resulting in reducing pathogenic strains, including C. acnes, S. aureus & Pseudomonas.*
*Based on a 4-week clinical study on subjects who used BLIS Q24™ twice daily, as measured using validated microbiome skin analysis software.

